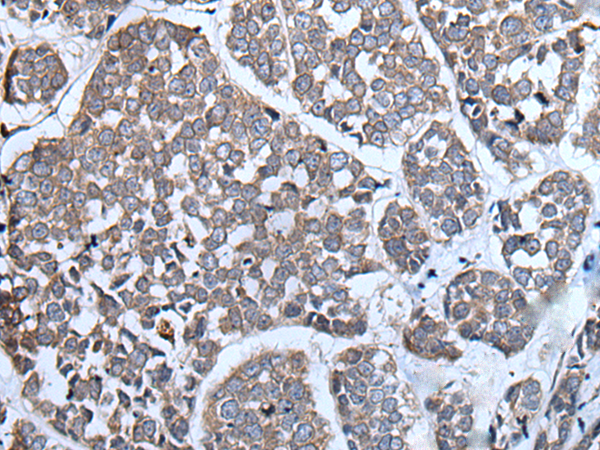
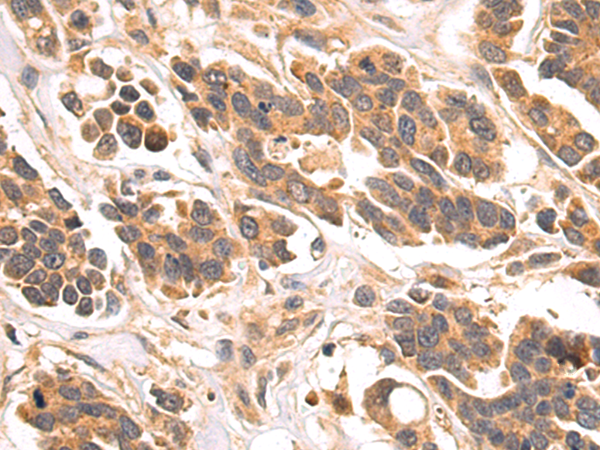

-
分类: 科研抗体货号: P00348别名: TIS8, AT225, G0S30, NGFI-A, ZNF225, KROX-24, ZIF-268应用: WB反应种属: Human, Mouse, Rat
-
分类: 科研抗体货号: P00310别名: HGB; STAP应用: IHC反应种属: Human, Mouse, Rat
-
分类: 科研抗体货号: P00400别名:应用: IHC反应种属: Human
-
分类: 科研抗体货号: P00344别名: E2F-6应用: WB,IHC反应种属: Human, Mouse
-
分类: 科研抗体货号: P00309别名: ACDP3应用: WB,IHC反应种属: Human, Mouse
-
分类: 科研抗体货号: P00397别名: GCS; GLCT1应用: WB,IHC反应种属: Human, Mouse, Rat
-
分类: 科研抗体货号: P00342别名: Dyna III应用: WB反应种属: Human, Mouse, Rat
-
分类: 科研抗体货号: P00307别名: CycC; SRB11; hSRB11应用: IHC反应种属: Human, Mouse, Rat
-
分类: 科研抗体货号: P00394别名: MLL/GAS7应用: WB,IHC反应种属: Human, Mouse, Rat
-
分类: 科研抗体货号: P00341别名: DR3, TR3, DDR3, LARD, APO-3, TRAMP, WSL-1, WSL-LR, TNFRSF12应用: IHC反应种属: Human

鄂公网安备42018502007531号
鄂公网安备42018502007531号

